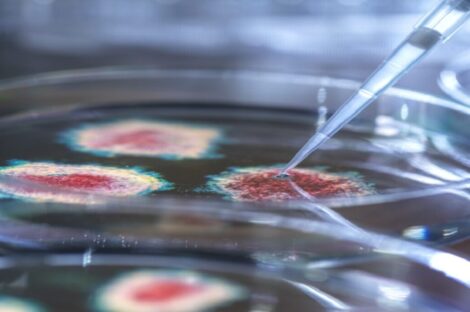

اكتشاف فيروس «غير مسبوق» قد يشكل تهديداً للبشر
أفادت صحيفة “ديلي ميل”، أنه تم “اكتشاف فيروس غير مسبوق، قد يشكل تهديدا للبشر في ولاية فلوريدا الأمريكية، ينتمي إلى…
أفادت صحيفة “ديلي ميل”، أنه تم “اكتشاف فيروس غير مسبوق، قد يشكل تهديدا للبشر في ولاية فلوريدا الأمريكية، ينتمي إلى…

أعلنت السلطات الصينية، اليوم الثلاثاء، تسجيل 32 إصابة جديدة بفيروس كورونا وعدم تسجيل أي حالة وفاة جديدة خلال الـ24 ساعة…

بعد أن أثارت الفنانة الكويتية، حياة الفهد جدلاً جراء تصريحات أدلت بها عن الوافدين، لا سيما المصابين بفيروس كورونا، يبدو أن الكرة…

أكشف فيديو واقع افتراضي مخيف، كيف ينتشر فيروس كورونا بسرعة عبر الرئتين، ما يتسبب في أضرار واسعة النطاق ومحتملة على…